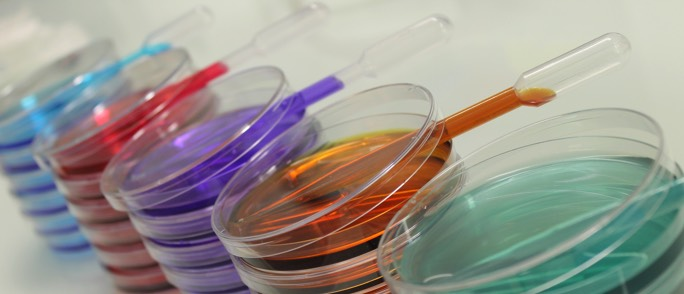
Boîtes

Le
RAEMA (Réseau d’Analyses et d’Echanges en Microbiologie des Aliments) est
un réseau d'intercomparaison en microbiologie des aliments.
Créé en 1988, il permet aujourd'hui à environ
400 laboratoires participants
de vérifier la qualité de leurs prestations.
L’ASA, organisateur du réseau est
accrédité par le Cofrac
sous le N°
1-1836 portée disponible sur www.cofrac.fr
depuis 2007 selon le
référentiel ISO 17043.
Le RAEMA permet aux laboratoires d'analyse d'évaluer leur compétence pour :
- la
recherche de
Salmonella et
Listeria monocytogenes
- le
dénombrement des
micro-organismes aérobies mésophiles, des
entérobactéries,
des
coliformes, d'
Escherichia coli, de
Clostridium perfringens,
des
staphylocoques à coagulase positive et de
L. monocytogenes.

Lors des deux campagnes annuelles d'intercomparaison, cinq échantillons artificiellement contaminés
sont envoyés aux participants et l'interprétation de leurs résultats permet d'évaluer
la
fidélité et la
justesse de leurs essais.
Chaque envoi donne lieu à un rapport qui permet aux laboratoires d'exploiter leurs résultats
et de les comparer à l’ensemble des résultats obtenus par les laboratoires participants.

Pour compléter cette offre classique, le
RAEMA gel incluant
deux campagnes d’intercomparaison annuelles supplémentaires a été mis en place en 2010.
Environ
100 laboratoires participent à ces campagnes et dénombrent les germes de leur choix parmi :
Bacillus cereus,
Pseudomonas,
Bactéries lactiques et
Levures / Moisissures.
Seule l’évaluation de la justesse est proposée lors de ces essais
et l’interprétation donne lieu à un rapport détaillant les résultats des laboratoires.
Télécharger la plaquette français
et english